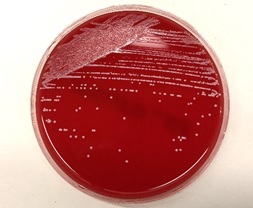

臨床検査科
更新日:2023年1月31日
概要
当科では医師の依頼により、病気の診断や治療効果を知るために必要な検査を臨床検査技師の国家資格を持った専門職が行っています。
検査は大きく「検体検査」と「生理機能検査」に分かれます。「検体検査」は患者さんから得られた血液、尿等に含まれる様々な成分を測定します。安全な輸血を行うための検査や血液製剤の管理・供給も行っています。「生理機能検査」は心電図・脳波・超音波検査などがあり、臓器の状態を調べます。
なお、中央採血室にて外来の採血も担当しています。
検体検査
生化学検査
血液や尿中に含まれる成分を測定し、健康状態や病態を評価します。
- 肝機能(AST・ALT・γ-GTP)
- 心機能(CK・トロポニンI・H-FABP)
- 腎機能(尿素窒素・クレアチニン・尿酸・尿タンパク)
- 脂質(総コレステロール・HDLコレステロール・LDLコレステロール・中性脂肪)
- 糖代謝(グルコース・HbA1c) など
【全自動生化学分析装置】

免疫血清検査
感染症の有無やがんが発生していないかを調べます。
- 感染症(B型肝炎・C型肝炎・梅毒・HIV)
- 腫瘍マーカー(CEA・AFP・PSAなど)
血液凝固検査
白血球や赤血球などに異常がないか、出血したときに正常に止血ができるかを調べます。
- 血球検査(白血球数・赤血球数・血小板数・形態検査)
- 凝固検査(PT・APTT・フィブリノゲン・Dダイマー) など
【全自動血球分析装置】

【末梢血液像】
一般検査
尿中に糖や蛋白、潜血などが出現しているか、尿中の成分から腎臓が障害されていないかを調べます。
- 尿定性検査(糖・蛋白・潜血・ケトン体・比重など)
- 尿沈渣検査(赤血球・白血球・細菌・上皮細胞・円柱類など)
- 便
【尿中結晶成分】

【膀胱癌患者で認められた異型細胞】

【尿定性分析装置と全自動尿中有形成分分析装置】

輸血検査
血液型を調べたり、輸血製剤と適合するかなどを検査します。
- 血液型検査
- 不規則抗体検査
- 交差適合試験 など
【全自動輸血検査装置】

【赤血球製剤】 【血小板製剤】

微生物検査
感染症が疑われる部位から採取した材料を用いて微生物を培養、同定をし、原因微生物を特定します。
- グラム染色
- 抗酸菌染色
- 培養同定検査
- 薬剤感受性検査
- 迅速抗原検査
- COVID-19 (PCR・抗原検査) など
【培養検査】
【鏡検時に認められた球菌】
病理検査
手術や生検で採取した臓器や組織を染色、鏡検することで疾病の確定診断などを行います。
- 組織診断
- 細胞診断
- 病理解剖 など
【婦人科の細胞診画像】

【胃癌の組織診画像】

生理機能検査
様々な検査機器を用いて患者さんの生体情報を直接調べる検査になります。
心電図検査
心臓の電気信号を記録し、不整脈の有無や心筋の状態を調べます。
ホルター心電図検査
24時間、心電計を装着して不整脈の種類・性状・発生頻度などを調べます。
マスター2階段負荷心電図検査
階段を昇降して、昇降前後の心電図変化を見ます。
超音波検査
心臓・腹部臓器・血管・体表臓器(甲状腺・乳腺・末梢神経等)など内部の構造を画像で調べます。
【超音波検査室】
〇血圧脈波検査(PWV/ABI)
〇脳波検査
〇神経伝導速度
〇筋電図検査
〇認知症検査
〇肺機能検査
〇聴力検査
特色
臨床検査技師が採血を担当することで、より迅速で精度の高い検査を行えます。外来診療でも、特殊な検査以外は診察前に結果を報告しています。休日や夜間も24時間対応しています。また、毎日内部で実施する精度管理のほかに第三者機関が行う外部精度管理にも積極的に参加し、高品質なデータの提供を実現しています。平成23年度から、日本臨床衛生検査技師会より「日臨技精度保証施設」として認証されています。
スタッフは自己研鑽に励んでおり、各種学会が認定する資格も多数取得し、検査の質の向上を図っています。これらの専門資格を活かして、医師と医療従事者が連携し患者様中心の医療を進める「チーム医療」に積極的に参画し、糖尿病教室、栄養サポートチーム、褥瘡対策、緩和ケア、院内感染対策等でも活躍しています。
各種学会が認定する資格も以下のように多くの技師が取得し、細胞診検査や超音波検査等、各認定技師が実施しています。
| 資格名 | 主な認定機関 | 認定者数(名) |
|---|---|---|
|
認定輸血検査技師 |
認定輸血検査技師制度協議会 | 2 |
| 認定臨床微生物検査技師(CMTCM) |
日本臨床微生物学会 日本環境感染学会 他 |
3 |
| 感染制御認定臨床微生物検査技師(ICMT) |
日本臨床微生物学会 日本環境感染学会 他 |
2 |
| 認定心電検査技師 | 日本臨床衛生検査技師会 | 4 |
| JHRS認定心電図専門士 | 日本不整脈心電学会 | 4 |
| 認定認知症領域検査技師 |
日本認知症予防学会 日本臨床衛生検査技師会 |
6 |
| 認定一般検査技師 | 日本臨床衛生検査技師会 | 1 |
| 認定救急検査技師 |
日本臨床救急医学会 日本臨床衛生検査技師会 |
2 |
| 認定病理検査技師 |
日本病理学会 日本臨床衛生検査技師会 |
1 |
| 認定超音波検査士 (6領域) |
日本超音波医学会
|
延べ 20 |
| 消化器領域 | 6 | |
| 体表臓器領域 | 6 | |
| 泌尿器領域 | 1 | |
| 産婦人科領域 | 3 | |
| 循環器領域 | 2 | |
| 健診領域 | 2 | |
| 認定臨床化学・免疫化学精度保証管理検査技師 |
日本臨床化学会 日本臨床衛生検査技師会 |
2 |
| 認定血液検査技師 | 日本検査血液学会 | 1 |
| 細胞検査士 CT(JSCC) |
日本臨床細胞学会 日本臨床検査医学会 |
3 |
| 国際細胞検査士 CT(IAC) | THE INTERNASIONAL ACADEMY OF CYTOLOGY | 1 |
| 二級臨床検査士 (8科目) |
日本臨床検査同学院 日本臨床検査医学会
|
延べ 54 |
| 微生物学 | 7 | |
| 病理学 | 5 | |
| 臨床化学 | 3 | |
| 血液学 | 12 | |
| 免疫血清学 | 7 | |
| 循環生理学 | 10 | |
| 神経生理学 | 3 | |
| 呼吸生理学 | 7 | |
| 緊急臨床検査士 |
日本臨床検査同学院 日本臨床検査医学会 |
8 |
| 糖尿病療養指導士 | 日本糖尿病療養指導士認定機構 | 2 |
| 臨床工学技士 | 厚生労働省 | 1 |
| 埼玉県肝炎コーディネーター | 埼玉県肝炎対策協議会 | 6 |
| 千葉県肝炎コーディネーター | 千葉県肝炎対策協議会 | 1 |
| 第2種ME技術者 | 日本生体医工学会 | 2 |
検査関係の施設認定資格一覧
| 資格名 | 認定機関 |
|---|---|
| 日本病理学会研修登録施設 | 日本病理学会 |
| 日本臨床細胞学会施設認定 | 日本臨床細胞学会 |
| 日本臨床細胞学会教育認定施設 | 日本臨床細胞学会 |
| 日本臨床検査医学会認定研修施設 | 日本臨床検査医学会 |
| 認定臨床微生物検査技師制度研修施設 | 日本臨床微生物学会 |
| 品質保証施設認証認定 | 日本臨床衛生検査技師会 |
| 精度認定 心臓領域・腹部領域 | 日本超音波検査学会 |
2026年2月現在
中央採血室
採血室では標準採血法ガイドライン(GP4-A3)に則って患者さんの検査のための採血や尿検査の受付を行っています。
~採血・採尿の流れ~
1.中央採血室は2階にあります。1階の再来受付機で受付を行い、2階に上がり赤い線の案内をたどってお越しください。
受付の開始時刻は8時15分です。採血時間は8時30分から16時30分までです。
2.採血・採尿受付機に1階の再来受付機で発行された受診案内票の右上にあるバーコードを読み込ませてください。
採血がある場合は整理券、採尿がある場合は尿カップが出てきます。
注:バーコードを読み込みする際、受付機の画面に「オーダ内容を確認します。採血受付にお尋ねください。」と表示された場合は採血室受付へお越しください。
注:採尿と採血のある方はどちらが先でも構いません。

~採血がある場合~
- 受付機から発行された整理券をお持ちになって中央採血室前でお待ちください。
- 採血の順番が近くなりましたら、中央採血室前の画面に番号が表示されますので中央採血室の中にお入りください。

- 中央採血室の中に入りましたら、長椅子にかけてお待ちください。速やかに採血ができるように袖をまくるなどの準備をお願いします。順番が来ましたら表示板に整理番号が表示されますのでそちらのブース内の椅子にお掛けください。


- 採血時に、気分が悪くなったことがある方や、止血に影響するお薬を飲まれている方、アルコールにアレルギーがある方は遠慮なさらずにお申し出ください。
- この後、採血された血液や提出された尿は検査室に運ばれて検査されます。
~採尿がある場合~
- 受付機の前の床に貼ってある緑の案内に沿って採尿室までお進みください。

- 採尿室の中に引き戸がありますのでそちらに提出してください。採血のある方は中央採血室前にお戻りください。
注:尿量など疑問がある際は小窓の奥のスタッフにお声がけいただくか、または「呼び出しボタン」にてお呼びください。
診療スタッフ紹介
| 医師名 | 役職 | 専門分野 | 備考 |
|---|---|---|---|
|
高瀬 優 |
科部長 |
人体病理学・病態学 |
日本病理学会専門医 |
